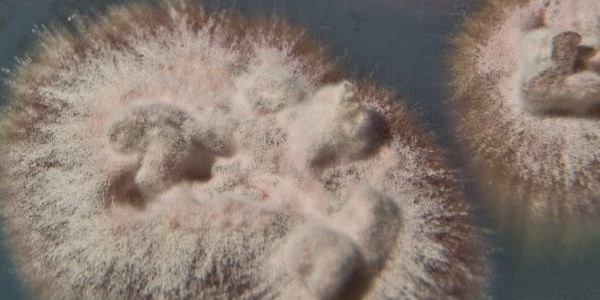
LABOPART Pilzgalerie

Les Geodermatophilales forment un ordre de bactéries gram positives de la classe des Actinomycetes. Il comprend des bactéries capables de vivre dans des sols très arides.
Description
Les bactéries de cet ordre sont des bactéries gram positives, aérobies et qui peuvent être mobiles.
Habitat
Cet ordre comprend de nombreuses souches bactériennes dont certaines Geodermatophilus capables de vivre dans des sols d'environnements arides ou hyper-arides.
Taxonomie
Le nom correct complet (avec auteur) de ce taxon est Geodermatophilales Sen et al. 2014.
Le genre type est : Geodermatophilus Luedemann 1968.
Geodermatophilales a pour synonyme :
- Antricoccales Salam et al. 2020
Étymologie
L'étymologie de cet ordre est la suivante : Ge.o.der.ma.to.phil.a’les. N.L. masc. n. Geodermatophilus, type genus of the order; L. fem. pl. n. suff. -ales, ending to denote an order; N.L. fem. pl. n. Geodermatophilales, the Geodermatophilus order. Le terme est construit sur les racines suivantes : Géo du grec ancien γῆ, gễ (la Terre), Dermato du grec ancien δέρματος, dérmatos (peau) et Phile du grec ancien φίλος, phílos (aimer, avoir une affinité).
Liste des familles
Initialement, l'ordre Geodermatophilales n'a compté qu'une seule famille, désormais, selon la base taxonomique LPSN (29 octobre 2023), il compte actuellement les deux familles suivantes :
- Antricoccaceae Nouioui et al. 2018
- Geodermatophilaceae Normand 2006
Références
Bibliographie
- Publication originale (en) Arnab Sen, Vincent Daubin, Danis Abrouk, Isaac Gifford, Alison M. Berry et Philippe Normand, « Phylogeny of the class Actinobacteria revisited in the light of complete genomes. The orders 'Frankiales' and Micrococcales should be split into coherent entities: proposal of Frankiales ord. nov., Geodermatophilales ord. nov., Acidothermales ord. nov. and Nakamurellales ord. nov. », Int J Syst Evol Microbiol, vol. 64, no 11, , p. 3821-3832 (DOI 10.1099/ijs.0.063966-0).
- (en) Maria Del Carmen Montero-Calasanz, Jan P Meier-Kolthoff, Dao-Feng Zhang, Adnan Yaramis, Manfred Rohde, Tanja Woyke, Nikos C Kyrpides, Peter Schumann, Wen-Jun Li et Markus Göker, « Genome-Scale Data Call for a Taxonomic Rearrangement of Geodermatophilaceae », Frontiers un Microbiology, eCollection 2017, vol. 8, no 2501, , p. 1-15 (PMID 29312207, DOI 10.3389/fmicb.2017.02501)
Liens externes
- (fr en) EOL : Geodermatophilales (consulté le )
- (fr en) GBIF : Geodermatophilales Non Valide (consulté le )
- (en) IRMNG : Geodermatophilales (consulté le )
- (en) LPSN : Geodermatophilales Sen et al. 2014 (consulté le )
- (en) NCBI : Geodermatophilales (taxons inclus) (consulté le )
- (en) Taxonomicon : Geodermatophilales Sen et al. 2014 (consulté le )
- Portail de la microbiologie